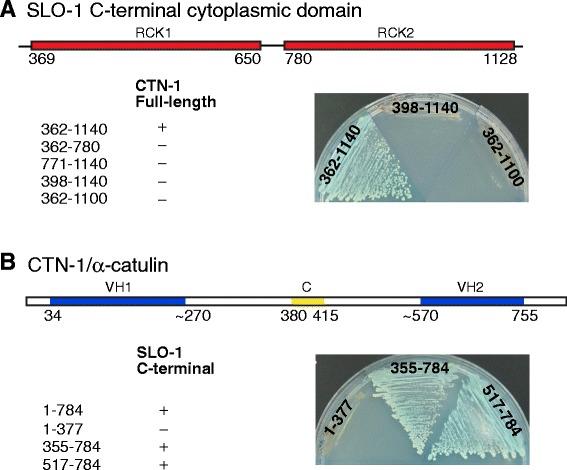
https://cdn.ncbi.nlm.nih.gov/pmc/blobs/db9d/4411755/cce41a4ca088/12868_2015_166_Fig1_HTML.jpg

突触前BK通道的定位依赖于α-钙调蛋白和肌萎缩蛋白的层级组织,并由CaV2钙通道进行微调。
Presynaptic BK channel localization is dependent on the hierarchical organization of alpha-catulin and dystrobrevin and fine-tuned by CaV2 calcium channels.
作者信息
Oh Kelly H, Abraham Linu S, Gegg Chandler, Silvestri Christian, Huang Yung-Chi, Alkema Mark J, Furst Jacob, Raicu Daniela, Kim Hongkyun
机构信息
Department of Cell Biology & Anatomy, Chicago Medical School, Rosalind Franklin University, 60064, North Chicago, IL, USA.
College of Computing and Digital Media, DePaul University, 60604, Chicago, IL, USA.
出版信息
BMC Neurosci. 2015 Apr 24;16:26. doi: 10.1186/s12868-015-0166-2.
BACKGROUND
Large conductance, calcium-activated BK channels regulate many important physiological processes, including smooth muscle excitation, hormone release and synaptic transmission. The biological roles of these channels hinge on their unique ability to respond synergistically to both voltage and cytosolic calcium elevations. Because calcium influx is meticulously regulated both spatially and temporally, the localization of BK channels near calcium channels is critical for their proper function. However, the mechanism underlying BK channel localization near calcium channels is not fully understood.
RESULTS
We show here that in C. elegans the localization of SLO-1/BK channels to presynaptic terminals, where UNC-2/CaV2 calcium channels regulate neurotransmitter release, is controlled by the hierarchical organization of CTN-1/α-catulin and DYB-1/dystrobrevin, two proteins that interact with cortical cytoskeletal proteins. CTN-1 organizes a macromolecular SLO-1 channel complex at presynaptic terminals by direct physical interaction. DYB-1 contributes to the maintenance or stabilization of the complex at presynaptic terminals by interacting with CTN-1. We also show that SLO-1 channels are functionally coupled with UNC-2 calcium channels, and that normal localization of SLO-1 to presynaptic terminals requires UNC-2. In the absence of UNC-2, SLO-1 clusters lose the localization specificity, thus accumulating inside and outside of presynaptic terminals. Moreover, CTN-1 is also similarly localized in unc-2 mutants, consistent with the direct interaction between CTN-1 and SLO-1. However, localization of UNC-2 at the presynaptic terminals is not dependent on either CTN-1 or SLO-1. Taken together, our data strongly suggest that the absence of UNC-2 indirectly influences SLO-1 localization via the reorganization of cytoskeletal proteins.
CONCLUSION
CTN-1 and DYB-1, which interact with cortical cytoskeletal proteins, are required for the presynaptic punctate localization of SLO-1 in a hierarchical manner. In addition, UNC-2 calcium channels indirectly control the fidelity of SLO-1 puncta localization at presynaptic terminals. We suggest that the absence of UNC-2 leads to the reorganization of the cytoskeletal structure that includes CTN-1, which in turn influences SLO-1 puncta localization.
背景
大电导钙激活钾通道(BK通道)调节许多重要的生理过程,包括平滑肌兴奋、激素释放和突触传递。这些通道的生物学作用取决于它们对电压和胞质钙升高协同响应的独特能力。由于钙内流在空间和时间上受到精确调节,BK通道在钙通道附近的定位对于其正常功能至关重要。然而,BK通道在钙通道附近定位的潜在机制尚未完全了解。
结果
我们在此表明,在秀丽隐杆线虫中,SLO-1/BK通道定位于突触前终末,其中UNC-2/CaV2钙通道调节神经递质释放,这是由CTN-1/α-连环蛋白和DYB-1/肌营养不良蛋白(两种与皮质细胞骨架蛋白相互作用的蛋白质)的层次组织所控制的。CTN-1通过直接物理相互作用在突触前终末组织一个大分子SLO-1通道复合物。DYB-1通过与CTN-1相互作用有助于该复合物在突触前终末的维持或稳定。我们还表明,SLO-1通道在功能上与UNC-2钙通道偶联,并且SLO-1在突触前终末的正常定位需要UNC-2。在没有UNC-2的情况下,SLO-1簇失去定位特异性,从而在突触前终末内外积累。此外,CTN-1在unc-2突变体中也有类似的定位,这与CTN-1和SLO-1之间的直接相互作用一致。然而,UNC-2在突触前终末的定位不依赖于CTN-1或SLO-1。综上所述,我们的数据强烈表明,UNC-2的缺失通过细胞骨架蛋白的重组间接影响SLO-1的定位。
结论
与皮质细胞骨架蛋白相互作用的CTN-1和DYB-1以层次方式是SLO-1在突触前点状定位所必需的。此外,UNC-2钙通道间接控制SLO-1在突触前终末点状定位的准确性。我们认为,UNC-2的缺失导致包括CTN-1在内的细胞骨架结构的重组,进而影响SLO-1点状定位。